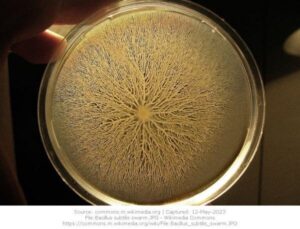
File Bacillus Subtilis

Sentient World Project includes your digital twins used for war games, war preparation, executing wars, performing mass-scale psychological operations, already controls billions of minds. Our bodies are being militarized.
Briefly covers: NSA, Digital Twin, Sentient World, Military, BigTech, AI, Propaganda, BRAIN Initiative, Internet of BioNanoThings, Neuralink, nanotechnology, Human Brain Indexing, Neurocapitalism, Mind Control, Smart Cities, World Economic Forum, Internet of Bodies (IoB), Meta, Virtual Reality, Web 3.0
TedX Sentient World Project, Digital Twins – Dirk Helbing [2022]
29 Apr 2022 YouTube | Rumble-Mirror | Download on Telegram
Who is Messing with Your Digital Twin? Body, Mind, and Soul for Sale? | Dirk Helbing | TEDxIHEID
In his talk, Dirk Helbing addresses the future of surveillance. The combined use of nano, digital, AI, and quantum technologies might lead society to a whole new level of surveillance. This would not only leave our privacy behind… Dirk Helbing is Professor of Computational Social Science at the Department of Humanities, Social and Political Sciences at ETH Zurich and affiliate of its Computer Science Department. Furthermore, he is member of the external faculty of the Complexity Science Hub Vienna.
Welcome to the digital age. You would be surprised what can be done today with big data and artificial intelligence.
For example, it’s possible to build a digital twin of planet Earth of climate, the environment and what’s going on on Earth. This is a highly detailed representation of all the activities and basically that is being mapped on a supercomputer.
Digital twins have been used also in order to optimize supply chains and also its processes to look into what if scenarios and also cities have been mapped by digital twins. Digital twins are also used in the health sector.
Digital twins are basically mapping body and mind in great detail. The question is how far should we go? Talking about smart cities, city life has been under a microscope already for some time. But should we put you under the microscope? In fact, this is what the NSA has been doing for quite some years now. We’ve learned about this from Edward Snowden back in 2013. ^01
And many of you have said at that time I’ve nothing to hide. Really? And is that even the point? Did you know for example that it is possible to find you through somebody else’s digital device where you are, what you say, can be translated in real time in other languages, can be searched for keywords. And this is not all. As you’ve learned from CIA director Gus Hunt back in 2013, you are already a walking sensor platform.
It is really within our grasp to be able to compute on all human generated information. What information is this? It’s coming, for example, from your smartphones. Your smartphone has a lot of sensors in it. And that can collect a lot of data that can be shared with tech companies and with secret services.
With all this data, you’re being profiled. All of you. And very great detail. In fact, those profiles contain information about where you live and where you work, what your income is, who your friends are, your family members, what your health situation is.
Even your personality, what you think and what you feel, all of this is being mapped by companies and actors you don’t even know.
Some people have suggested, well, this could be used actually to improve democracy. Do we need politicians at all? When a supercomputer knows everything about us, including what we think and feel and what we want, couldn’t a supercomputer and AI system do a much better job? Well, perhaps we should think twice before we implement a post-voting society. Because what if your digital twin does not represent your opinions well? What if the data is manipulated or hacked? What if you change your mind? Would you still be listened to? Or would they listen to your digital twin instead? And are they really concerned about your opinions and democratic representation or rather about making you do what they want?
In fact, I want to tell you about a project called Sentient World Project and it’s run by the military together with Fortune 500 companies. This is a giant computer simulation of everything that happens on Earth. It includes your digital twins, all of your digital twins, as being used for war games, for war preparation, for executing wars, and also for performing psychological operations so-called PsyOps on a mass scale.
Tristan Harris, who’s worked in a Google Control Room, has informed us that a handful of 10 companies today already control billions of minds every day, including yours. ^02
And how does that work? Well, you should know actually because of the Cambridge Analytica scandal. And also because of movies such as The Social Dilemma. Basically, all this data that’s being collected through your social media activity, but also all the other data is being used to get a better and better picture of you, how you think and feel, how your mind works, what’s your strengths and weaknesses. And this is being used to personalize information and manipulate you. And that has been done, for example, during the Brexit vote, has been done for many years in more than 60 democratic countries.
We saw that were democratic elections, in fact, all of that had been manipulated. And the tool is called propaganda. Also, by the way, public relations goes back to people like Edward Bernays, has been instrumental for World War I, for Hitler’s Third Reich, for World War II, and many other events. ^03
Now these methods have been perfected. They’ve been personalized. They basically can manipulate you without you even noticing. With weaponized propaganda AI that knows you better than you know yourself, these systems can manipulate you better than your friends. And so warfaring today is about behavioural change. And this is happening 24-7 every day.
These methods are highly effective. Military methods can be also a times relentless and even brutal. So now you know who is messing with your digital twin. It’s big tech companies. Also, by the way, advertisement companies, and it’s the military. ^04
And when they’re messing with your digital twin, basically, they’re trying to mess with you. They’re playing something like RoboChess with you. They’re playing with you. They’re making you do certain kind of things.
And how do they do this? They know about the cognitive prices of the brain and they’re using them against you to trick you and manipulate you. And the secret services have found ways to digitize that and to automate that and have AI use these tricks against you.
How effective is it? Let me give you an example. Back on June 22, 2020. A violent mob stormed the city of Stuttgart, very surprisingly so. The police was shocked. The public was shocked. Nobody could make sense of what was happening at that time. ^05
Actually, scientists think this might have been an instance of footfall. Sensitive people have been targeted with provocative content to make them upset, to make them go mad and to make them go into prison, in fact.
Targeting people is dangerous. It’s dangerous not only for individuals, it’s also dangerous for democracies that are being replaced by data-driven societies increasingly. You could say by data dictatorships.
And it doesn’t stop there. The main surveillance is next and even in-body surveillance.
It’s now possible to measure heartbeats from a distance and they’re trying to do the same thing with EEGs.
And there is a $3 billion brain project. The mission of that project is to deepen the understanding of the inner workings of the human mind and to improve how we treat, prevent and cure disorders of the brain, including unwanted behaviours. ^06 ^07
How does it work? Basically, engineers are working now to build a wireless body area network. And an internet of bio-nanothings. So our bodies are being exposed to nanoparticles. These are minute particles much smaller than the diameter of a hair, which are absorbed by our body and can be used to read out data and also to manipulate processes in the body. ^08
You’ve certainly heard about Elon Musk’s NeuraLink project. He wants to implant computer chips into people’s brains and connect them with supercomputers to create super humans. Actually I think that’s outdated technology. ^09
In the meantime, scientists were working on nanotools for brain activity mapping. And this is going to be a billion-dollar business. They’re trying to do human brain indexing, including your brain. And why are they doing it? Because surveillance capitalism knows where you are, what you do, what you see, what you buy. And they want to be able to control what you think, what you feel, what you do, how you behave. And this is what neurocapitalism would be about.
So we’re heading towards brain reading technology.
We’re heading towards mind control. ^10 ^11 ^12
And the law is not ready to protect us. If you want to get an idea, how far that could go, then you could read that science fiction novel with a trillion sensors feeding data into a central computer unleashed into the world, governments, militaries, mega corporations, dictators, and even hackers will be able to hear the heartbeat of the earth. And your heartbeat too. Already companies are starting to exploit our most intimate data.
Your health data is being stolen. Stealing this kind of data can be used to heal and to kill.
So is our body now being militarized? Is it going to be part of the global battlefield, controlled remotely, digitally? Well, we need to be cautious.
The World Economic Forum has informed us back in 2020, tracking how our bodies work, who change our lives. Well, of course. And they also told us the Internet of Bodies is already here. ^13 ^14
So our digital twins already exist.
And you could have guessed because Facebook was renamed into Meta and Mark Zuckerberg was producing a big advertisement movie, 90 minutes long. What do you think was Mark Zuckerberg actually speaking to you himself or was it his avatar? ^15
For sure, digital twins need ethics and rights. And that became obvious right in the beginning when the MetaVerse was launched. People started immediately to abuse other people’s digital twins. So measures had been taken to restore human dignity and safety. They had to introduce social distancing in the virtual reality.
Did you know, by the way, what was Prince’s biggest fear? Well, long before holograms existed, he said that whole virtual reality thing, it really is demonic. And why did he say that? Because Michael Jackson had died a couple of years earlier, back in 2009. And five years after that, he virtually stepped out of his grave to give a live performance and present a new song called Slave to the Rhythm. In that song, the misery of peace and love, Michael Jackson was basically turned into a dark overload promoting technological totalitarianism. ^16 ^17
Such things should not be allowed to happen. We need to be in control of the data making up our digital twins. And we need a platform for informational self-determination. Perhaps the web 3.0 could save us. We’ll have to see. But that’s make sure to free our digital twins from virtual captivity and abuse. Because in times of the matrix where we are increasingly controlled in digital ways, we cannot be free if our digital twins are not.
- How We Win | Legal & Mankind Remedy
- Aussies to Merge Brain Cells with AI
- WEF Parody vs Real Compilation Vids
- Pfizer switched templates that could cause permanent genome changes to those injected & their offspring…[Senate Hearing]
- Sentient World – Militarizing our Bodies
- The Great Awakening [Documentary]
- [chatGPT] NBIC (Nano-Bio-Info-Cogno)
- Bioengineered Clathrin Quantum Cognitive Sensors (ExQor / ExQori∆ / Xenqai)
- NBIC (Converging Humans with Tech) Links
- David Rockefeller – A Brief Timeline
- Hackable Humans [Short Compilation Video]
- The Sequel to the Fall of the Cabal [Documentary]
- 5G-Covid-19 Paper
- [Legal] Bioweapon evidence [May 23, 2023]
- Must watch: Sci-Fi Short Film “Nano” | DUST
- [2015] Self-Assembling Nano, Smart Dust, Geo-Engineering since 1945
- [Part III] Mass-mind-control (2000-2022)
- Covid Vaccines deliver 5G Nanotechnology (La Quinta Columna)
- Dr. Alphonzo Monzo – Detox Nanotech
- Fundamentals of Molecular Nano-Communication Networks [Lecture]
References/Footnotes:
- NSA Goal Is ‘Total Population Control’ https://pennybutler.com/nsa/ ↥
- April 2017 How a handful of tech companies control billions of minds every day https://www.ted.com/talks/tristan_harris_how_a_handful_of_tech_companies_control_billions_of_minds_every_day ↥
- Edward Bernays https://en.wikipedia.org/wiki/Edward_Bernays ↥
- James Giordano: 2017, 2018, 2020, 2021, 2022 Compilation https://pennybutler.com/giordano-2017-2022/ ↥
- 2020 Stuttgart riot https://en.wikipedia.org/wiki/2020_Stuttgart_riot ↥
- Brain Initiative: Want Millions To MK Ultra Humanity? Job Opportunities https://pennybutler.com/brain-initiative-job-opportunities/ ↥
- Magnetic Phenomenon & The Graphene Flagship https://pennybutler.com/game-is-over-part2e/ ↥
- Internet Of Bio-NanoThings https://pennybutler.com/internet-of-bio-nanothings/ ↥
- Elon Musk’s Connection With Graphene Oxide https://pennybutler.com/elon-musk-neuralink/ ↥
- “Voice In Your Head” Military Weapon Only You Can Hear & Other Mass-Mind-Control Methods Since The 1940s https://pennybutler.com/mass-mind-control/ ↥
- [Part II] Mass-Mind-Control (1945-1999) https://pennybutler.com/part-ii-mass-mind-control/ ↥
- [Part III] Mass-Mind-Control (2000-2022) https://pennybutler.com/part-iii-mass-mind-control/ ↥
- Jun 4, 2020 World Economic Forum Tracking how our bodies work could change our lives https://www.weforum.org/agenda/2020/06/internet-of-bodies-covid19-recovery-governance-health-data/ ↥
- 6 August 2020 World Economic Forum The Internet of Bodies Is Here: Tackling new challenges of technology governance https://www.weforum.org/reports/the-internet-of-bodies-is-here-tackling-new-challenges-of-technology-governance ↥
- The Metaverse and How We’ll Build It Together — Connect 2021 https://youtu.be/Uvufun6xer8 ↥
- Slave to the Rhythm (Michael Jackson song) https://en.wikipedia.org/wiki/Slave_to_the_Rhythm_(Michael_Jackson_song) ↥
- Michael Jackson – Slave To The Rhythm https://youtu.be/jDRTghGZ7XU ↥
Site Notifications/Chat:
- Telegram Post Updates @JourneyToABetterLife (channel)
- Telegram Chatroom @JourneyBetterLifeCHAT (say hi / share info)
Videos: